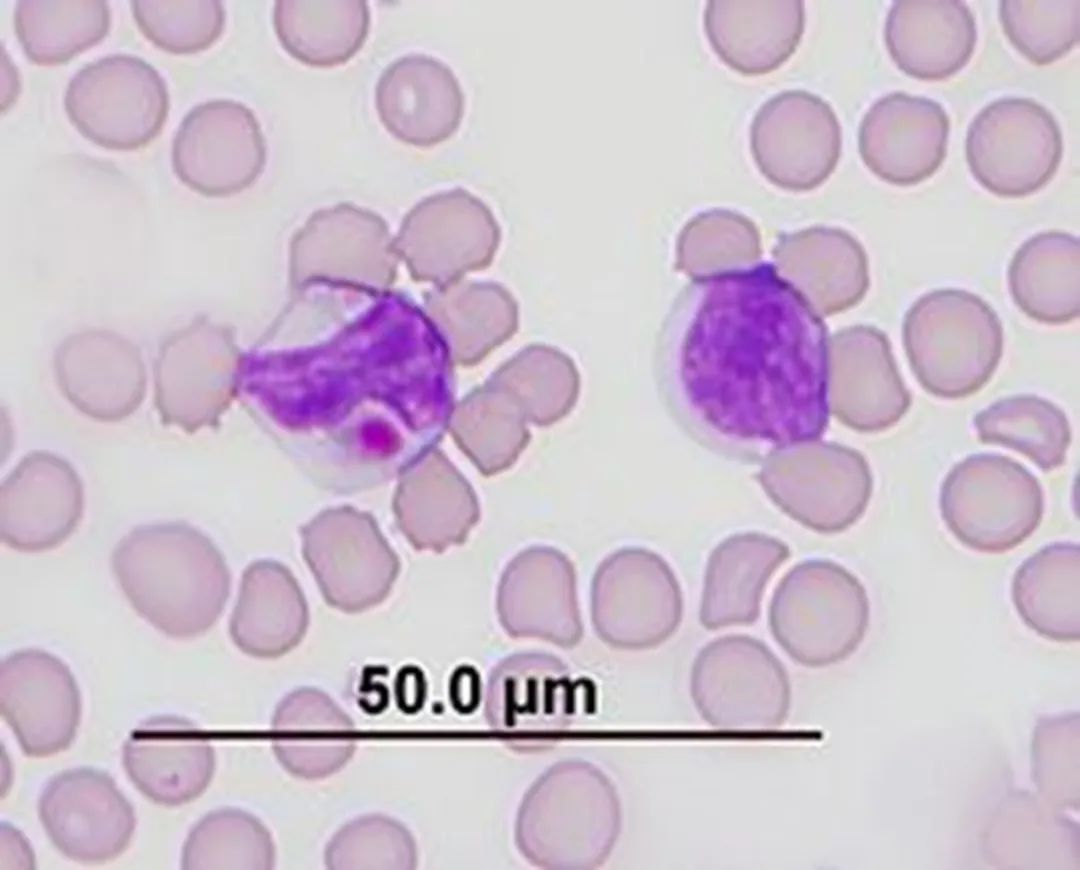
2.jpg 2.jpg

啮齿类动物血常规结果分析注意事项
血液学检查是动物疾病状态评估,术前检查和常规体检中必不可少的内容,评估血常规检测报告的可靠性并解读其结果是兽医朋友们的工作日常,本文就血液学检查的一些要点进行分析探讨 蜜桃影视。
采血是进行血常规检查的第一步,本公众号曾经发表《兽医随笔:实验动物采血指南》一文 蜜桃影视在线,介绍采血量和采血点的一般指导意见。
进行血液学分析时通常建议用EDTA抗凝管采集样本 蜜桃影视高清,但采集时应该注意抗凝剂和血液的比例,样本质量会显著影响检测结果,常见的样本质量问题有:。
抗凝效果不佳导致出现血凝块,会使血小板(PLT) 蜜桃影视免费观看,白细胞(WBC),红细胞(RBC),红细胞压积(HCT)假性降低.
溶血会使RBC. HCT假性降低的同时平均红细胞血红蛋白浓度(MCHC). 平均红细胞血红蛋白(MCH)假性升高 在线影视.
乳糜血会使血红蛋白(Hb) 蜜桃视频. MCHC. MCH假性升高.
样本不新鲜会使红细胞形态发生改变导致MCV和HCT假性升高 蜜桃影视,MCHC假性降低,同时白细胞形态也会发生改变。
红细胞 蜜桃影视在线,白细胞和血小板是血常规报告中需要解读的三个方面。
红细胞
相比于人及其他哺乳类动物,啮齿类动物的红细胞自有其特征。仓鼠的RBC约6,0微米,豚鼠的约7,8微米。大鼠出生时红细胞较大(10,03 μm),但在出生后30天内变到小于6μm。小鼠RBC大小约4-7μm,随年龄增长而增加。多色性是啮齿类动物血象的一个常见特征。在豚鼠血涂片上还可见红细胞叠连。特定疾病模型小鼠中,如β地中海贫血模型小鼠RBC可观察到异常形态,例如靶形红细胞、棘形状红细胞、泪滴状红细胞、破碎状红细胞、有核红细胞等。 蜜桃影视高清。

(图片来源:https://www. researchgate. net/publication/233535082) 蜜桃影视免费观看.
和大多数哺乳动物(包括人)不同的是,新生啮齿类动物(小鼠、大鼠、豚鼠、沙鼠)的血红蛋白和血细胞比容值低于成年动物;新出生大鼠有16%的网织红细胞,成年后则减少至2.5%;据报道,大鼠、沙鼠的RBC计数存在性别差异,雌性的计数通常比雄性高。不同品系的小鼠和大鼠,血红蛋白值也会有很大的差异。
样本采集部位或麻醉的影响会导致血常规数据的变化。例如,从大鼠尾部采集的样本中的血红蛋白和红细胞比容比从腹主动脉或心脏中采集的样本中要高。豚鼠中已经证实RBC值可能由于麻醉期间发生脾内红细胞扣留而降低。
影响RBC参数的非致病性条件还包括妊娠、季节变化等。在大鼠中,红细胞比容在妊娠期间减少。在仓鼠中,RBC计数、血红蛋白浓度和红细胞比容在冬眠期间升高,这是因为在冬眠期间,仓鼠基础代谢率降低,RBC寿命延长了。
红细胞和贫血
红细胞指标重点关注RBC、HCT和Hb,它们的变化可以提示动物贫血或红细胞增多。
啮齿类动物中并没有原发性的红细胞增多症,但可能见于轻度脱水的动物。贫血则较为常见。初步判断为贫血后,还需要关注平均红细胞体积(MCV),MCH和MCHC,可用于辅助判断贫血类型,这三项都偏低常见于缺铁性贫血,而高于正常范围多见于叶酸或维生素B12缺乏引起的贫血。网织红细胞是尚未完全成熟的红细胞,是反映骨髓造血功能的重要指标。当其升高时,提示骨髓造血功能旺盛,可能有溶血性贫血、缺铁性贫血等;而当其降低时,可能有再生障碍性贫血、急性白血病等。
仪器分析的血常规化验单只能给出各种细胞的数量,但并不能给出细胞形态的异常描述。因此为了更准确分析血液学检查结果还建议对血样涂片进行形态学检查。
RBC形态学可区分贫血的原因:出血、溶血、缺铁、非再生性贫血、骨髓疾病或淋巴细胞增生性疾病(白血病)等。
如果诊断为溶血性贫血,则需要在血涂片中寻找血液寄生虫的证据,如球状附红细胞体和鼠血巴尔通体可能导致小鼠或大鼠贫血。如果出现小红细胞增多症、血色素减少、总蛋白低、血小板增多和网织红细胞计数升高则提示有慢性失血,建议检查体表寄生虫,在虱子严重感染的豚鼠和大鼠中可见这种现象。
白细胞
白细胞是机体抵御感染、调控炎症、免疫和造血的关键。
啮齿类动物的白细胞形态和其他哺乳动物相似,但又有一定区别,啮齿类动物的粒细胞被称为嗜异性或假嗜酸性粒细胞,因为它含有红色颗粒,与嗜酸性粒细胞相似。豚鼠有独特的Foa-Kurloff细胞(一种T淋巴细胞),含有一个大的细胞质包涵体。啮齿类动物的白细胞类型与其他哺乳动物相似,但淋巴细胞数量远超过粒细胞:淋巴细胞约占86%,中性粒细胞约占10% ~ 25%,单核细胞约占6%,嗜酸性粒细胞约占1% ~ 4%,嗜碱性粒细胞很少。
WBC计数每天都会发生波动,因此采集样本的位置和时间不同,结果也可能不同。中性粒细胞计数随着大鼠年龄的增长而增加,淋巴细胞计数随着年龄的增长而减少。
豚鼠的Kurloff 细胞
(图片来源:https://en.wikipedia.org/wiki/Kurloff_cell)
白细胞:淋巴细胞
淋巴细胞增多
淋巴细胞分为T淋巴细胞和B淋巴细胞,大多在外周淋巴组织中生成并在血液和淋巴组织中循环。淋巴细胞的增多大多为生理性的。反应性淋巴细胞增多的原因包括注射疫苗后的短暂反应、长期免疫刺激、甲状腺功能亢进等;肾上腺皮质功能减退也会导致淋巴细胞增多,并常伴随低血糖、电解质异常,出现高钾低钠和高钙血症;淋巴瘤、胸腺瘤可见淋巴细胞异常升高,淋巴细胞性白血病则在淋巴细胞异常升高的同时伴有其他细胞系的减少。
淋巴细胞减少
淋巴细胞减少最常见的原因是内外源性皮质类固醇激素增多,导致其从血液循环中转移到淋巴组织中。在急性炎症反应、病毒感染以及发生内毒素血症和败血症时,也可见淋巴细胞减少。免疫缺陷病毒感染、免疫抑制药物的使用也会让淋巴细胞生成减少。淋巴回流受阻或丢失也会让其计数减少。

(A)淋巴细胞,特征是有深紫色圆形核;(B)单核细胞,特征是有肾形细胞核;(C)中性粒细胞,特征为有紫色多小叶细胞核。
(图片来源:Bjorner & Zhu, 2019)
白细胞:中性粒细胞
中性粒细胞增多
与其他哺乳动物一样,急性炎症反应的特征是中性粒细胞增多并有核左移。但并不是出现中性粒细胞增多就意味着急性炎症反应,动物经历剧烈运动、惊吓伤心等强烈情绪后也可出现生理性中性粒细胞增多,但不会出现核左移。
应激或皮质类固醇也可导致动物出现中性粒细胞数量增加,无左移。
此外慢性粒细胞性白血病、中性粒细胞功能障碍也可使中性粒细胞数量增加,同时出现核左移、多组织髓外生成粒细胞、血小板减少等异常。

正常情况下,外周血液中性粒细胞以分叶核为主,胞核常分为2~5叶,杆状核较少。中性杆状核粒细胞增多或(和)出现晚幼粒细胞、中幼粒细胞,甚至原始/早幼粒细胞的现象,称为核左移。
中性粒细胞减少
中性粒细胞减少也非常常见,其中临床常见的因素为严重的细菌感染,例如肺炎、败血症、腹膜炎等,常会伴随核左移和中毒性变化。骨髓疾病、药物毒性、病毒感染和肿瘤等也可造成中性粒细胞减少,同时可能会伴有红细胞和血小板的减少。
白细胞:嗜酸性粒细胞
嗜酸性粒细胞主要聚集在皮肤、消化道和呼吸道黏膜等疏松结缔组织中,它的增多常见于寄生虫感染的动物和发生I型超敏反应的动物。也由于其分布特点,大多血液寄生虫不会引起嗜酸性粒细胞增多。此外,还有一些临床原因可导致嗜酸性粒细胞增多,比如嗜酸性粒细胞性肠炎、嗜酸性肌炎等炎症反应;某些能促进嗜酸性粒细胞生成和释放的肿瘤(淋巴瘤、鳞状细胞癌等);肾上腺皮质机能减退等。
白细胞:嗜碱性粒细胞
嗜碱性粒细胞参与迟发性过敏和寄生虫免疫反应,因此嗜碱性粒细胞增多症常和嗜酸性粒细胞增多症同时发生。此外还可见于高脂血症、嗜碱性粒细胞性白血病和骨髓增生性疾病。
白细胞:单核细胞
单核细胞等主要功能是吞噬作用、调节炎症反应、参与抗原提呈、参与铁的调节。因此当机体出现急性或慢性炎症、组织坏死时,都会导致单核细胞增多。中性粒细胞减少时也会出现单核细胞代偿性增加。其他不常见的原因还包括应激或类固醇、单核细胞白血病等。啮齿类动物中,多达25%的F344大鼠会发生单核细胞性白血病。发病动物外周血中,可见非典型性单核细胞,白细胞计数极度增高和溶血性贫血。
血小板
血小板为骨髓巨核细胞胞浆裂解脱落的小块胞质,其主要作用是凝血和止血,修补破损血管。啮齿类动物的血小板数量和凝血过程与其他哺乳动物相似。在小鼠、大鼠或豚鼠中,未观察到血小板计数的性别或品系差异。大鼠的血小板会聚集,计数往往不可靠。
血小板减少
血小板减少症发生时,动物可出现瘀斑、瘀点、黏膜出血、止血困难等。但血液分析仪判读为血小板减少时,应做血涂片确认是否发生凝集,因为血小板做血液采集、运输、储存过程中会活化并凝集进而影响机器读取数据。通过无创性静脉穿刺采血、使用柠檬酸盐抗凝剂、减少采样后储存时间、避免低温等措施可以减少这种影响。
通常血小板减少是一过性的,跟多种系统性疾病都有关联,随着疾病的康复,血小板计数也会恢复正常。持续性的或进行性的血小板减少症表明血小板生成或消耗持续失衡。例如血小板减少伴随白细胞减少和(或)贫血通常提示骨髓疾病引起的造血功能障碍;免疫介导的破坏等。
血小板增多
血小板计数增多可能由原发性血小板增多症、骨髓增殖性疾病和继发性血小板增多症引起。


